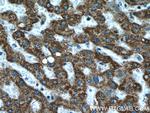
ATPB Antibody in Immunohistochemistry (Paraffin) (IHC (P))

Search
Proteintech
ATPB Polyclonal Antibody
{{$productOrderCtrl.translations['antibody.pdp.commerceCard.promotion.promotions']}}
{{$productOrderCtrl.translations['antibody.pdp.commerceCard.promotion.viewpromo']}}
{{$productOrderCtrl.translations['antibody.pdp.commerceCard.promotion.promocode']}}: {{promo.promoCode}} {{promo.promoTitle}} {{promo.promoDescription}}. {{$productOrderCtrl.translations['antibody.pdp.commerceCard.promotion.learnmore']}}
产品信息
17247-1-AP
种属反应
已发表种属
宿主/亚型
分类
类型
抗原
偶联物
形式
浓度
规格
纯化类型
保存液
内含物
保存条件
运输条件
产品详细信息
Immunogen sequence: EILVTGIKV VDLLAPYAKG GKIGLFGGAG VGKTVLIMEL INNVAKAHGG YSVFAGVGER TREGNDLYHE MIESGVINLK DATSKVALVY GQMNEPPGAR ARVALTGLTV AEYFRDQEGQ DVLLFIDNIF RFTQAGSEVS ALLGRIPSAV GYQPTLATDM GTMQERITTT KKGSITSVQA IYVPADDLTD PAPATTFAHL DATTVLSRAI AELGIYPAVD PLDSTSRIMD PNIVGSEHYD VARGVQKILQ DYKSLQDIIA ILGMDELSEE DKLTVSRARK IQRFLSQPFQ VAEVFTGHMG KLVPLKETIK GFQQILAGEY DHLPEQAFYM VGPIEEAVAK ADKLAEEHSS (181-529 aa encoded by BC016512)
靶标信息
ATP synthase is extremely conserved through evolution and can be found in plants, fungi, bacteria, and animals. The ATP synthase enzyme is a transmembrane protein responsible for driving the reversible reaction from ADP+ phosphate to ATP. This reaction is accomplished by a flux of protons across the membrane as a result of electron transfer. The ATP synthase protein has two main sections; the F1 ATP-ase (soluble) and the F0 ATP-ase (membrane embedded). The F1 section consists of the alpha, beta, gamma, delta, and epsilon subunits. While the F0 consists of a, b, and c subunits.
仅用于科研。不用于诊断过程。未经明确授权不得转售。
生物信息学
蛋白别名: ATP synthase F(1) complex catalytic subunit beta, mitochondrial; ATP synthase F(1) complex subunit beta, mitochondrial; ATP synthase F1 subunit beta; ATP synthase subunit beta, mitochondrial; ATP synthase, H+ transporting mitochondrial F1 complex, alpha subunit; ATP synthase, H+ transporting mitochondrial F1 complex, beta subunit; ATP synthase, H+ transporting, mitochondrial F1 complex, beta polypeptide; Atp5b; epididymis secretory protein Li 271; MGC5231; mitochondrial ATP synthase beta subunit; mitochondrial ATP synthase, H+ transporting F1 complex beta subunit; mitochondrial ATP synthetase, beta subunit; unnamed protein product
基因别名: ATP5B; ATP5F1B; ATPMB; ATPSB; HEL-S-271; HUMOP2
UniProt ID: (Human) P06576, (Rat) P10719, (Mouse) P56480
Entrez Gene ID: (Human) 506, (Rat) 171374, (Mouse) 11947